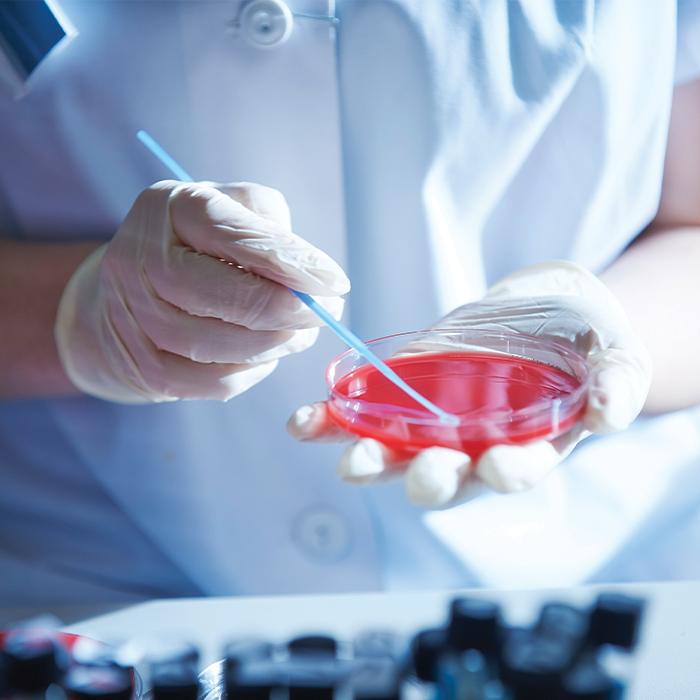

Microbiology
Under the guidance of Prof Dr. Essa M Abdulla and currently headed by Dr Farheen, our Department of Microbiology is well known in both professional and patient circles. Dr Essa Laboratory and diagnostic center is credited for providing urgent and accurate results.
Immunology & Serology
Laboratory is pioneer in testing and providing various serological test including Typhoid, ICT Falciparum Malaria, Dengue Rapid Antigen Detection test, ICT Mycobacteria, Flex pock Helicobacter Pylori Antibodies, Anti CCP, Vitamin D3, Troponin I and T etc. Our Lab also conducts PCR, HIV, Hepatitis B & C available on Real Time Automated Machine: Electrophoresis & other specialized tests

Histopathology
Dr Essa Laboratory is a recognized histopathology center in Karachi. We are proud to have Qualified MRCPath, FRCPath, MCPS & FCPS staff consultants who conduct FNAC’s and Bone Marrow Aspiration and Biopsies in our facility

Molecular Pathology
Dr. Essa Laboratory & Diagnostic Centre makes another study breakthrough in clinical molecular diagnostics by being enlisted in very few of those having Molecular Pathology Department in Pakistan. In the era where availing Molecular Diagnostic Services is beyond the reach. We’ve been working with the highest quality standard and patient care with unrivaled competitive rates and shortest report turn around time. Our convergence is on the provision of quality health of patient, where targeted DNA/RNA even be in very minute quantities. Thus, even in Molecular diagnostics we ae strictly following closed system testing with no open bench work consequently ensuring the excellence of results. All the working are performed by the team of qualifies, trained and experienced molecular pathologists working under the control and directions of Head Molecular Pathologist.

Clinical Biochemistry
The department is characterized by modern technology to ensure fast and reliable results of laboratory tests. The department’s work is very varied and ranges from analysis to teaching and quality control. For example, the work comprises of the following aspects majorly
- Taking blood samples in the outpatient clinic and in the outpatient ward
- Analyzing blood, serum & plasma, hormone and urine
- Analysis of material from other hospitals, collection & research units Preparing production statistics and running quality assurance and analysis
- Testing & data handling of results for research projects
- Internal and External Quality Control and assurance

Haematology
The department runs a diagnostic Haematology service which is a rapid access facility for new and follow-up patients with a range of blood diseases. This includes testing and advice on a wide range of haematological conditions. Many but not all tests are automated. Complete results including microscopy are performed by Haematology medical staff under Supervision of USA Qualified & Trained Haem/Onco Consultants. We focus our energies on the diseases of the blood, problems with the blood-forming organs, solid cell tumors, and the health of the patient or the person as a whole. We have active Haematology Dept
